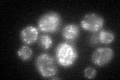
YPL270W
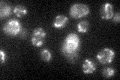
YPL270W

View description
Mitochondrial inner membrane half-type ATP-binding cassette (ABC) transporter, required for respiratory growth at high temperature; similar to human TAP1 and TAP2 implicated in bare lymphocyte syndrome and Wegener-like granulomatosis
Localization:
Intensity:
Fold change:
Significance:
-
C’ GFP library in SD

mitochondria28.98 -
N' NOP1pr-GFP in SD

N/A0 -
N' TEF2pr-mCherry in SD

N/A0 -
N' NATIVEpr-GFP in SD

N/A0 -
N' TEF2pr-VC and Cyto-VN in SD

N/A0 -
C’ GFP library in SD+DTT
mitochondria31.781.09No -
C’ GFP library in SD+H2O2

vacuole membrane29.961.03No -
C’ GFP library in Starvation Media
mitochondria40.081.38Yes -
C’ GFP library on the background of Pup2-DaMP

mitochondria -
C’ GFP library on the background of CCT mutant

mitochondria23.9530.82626No
